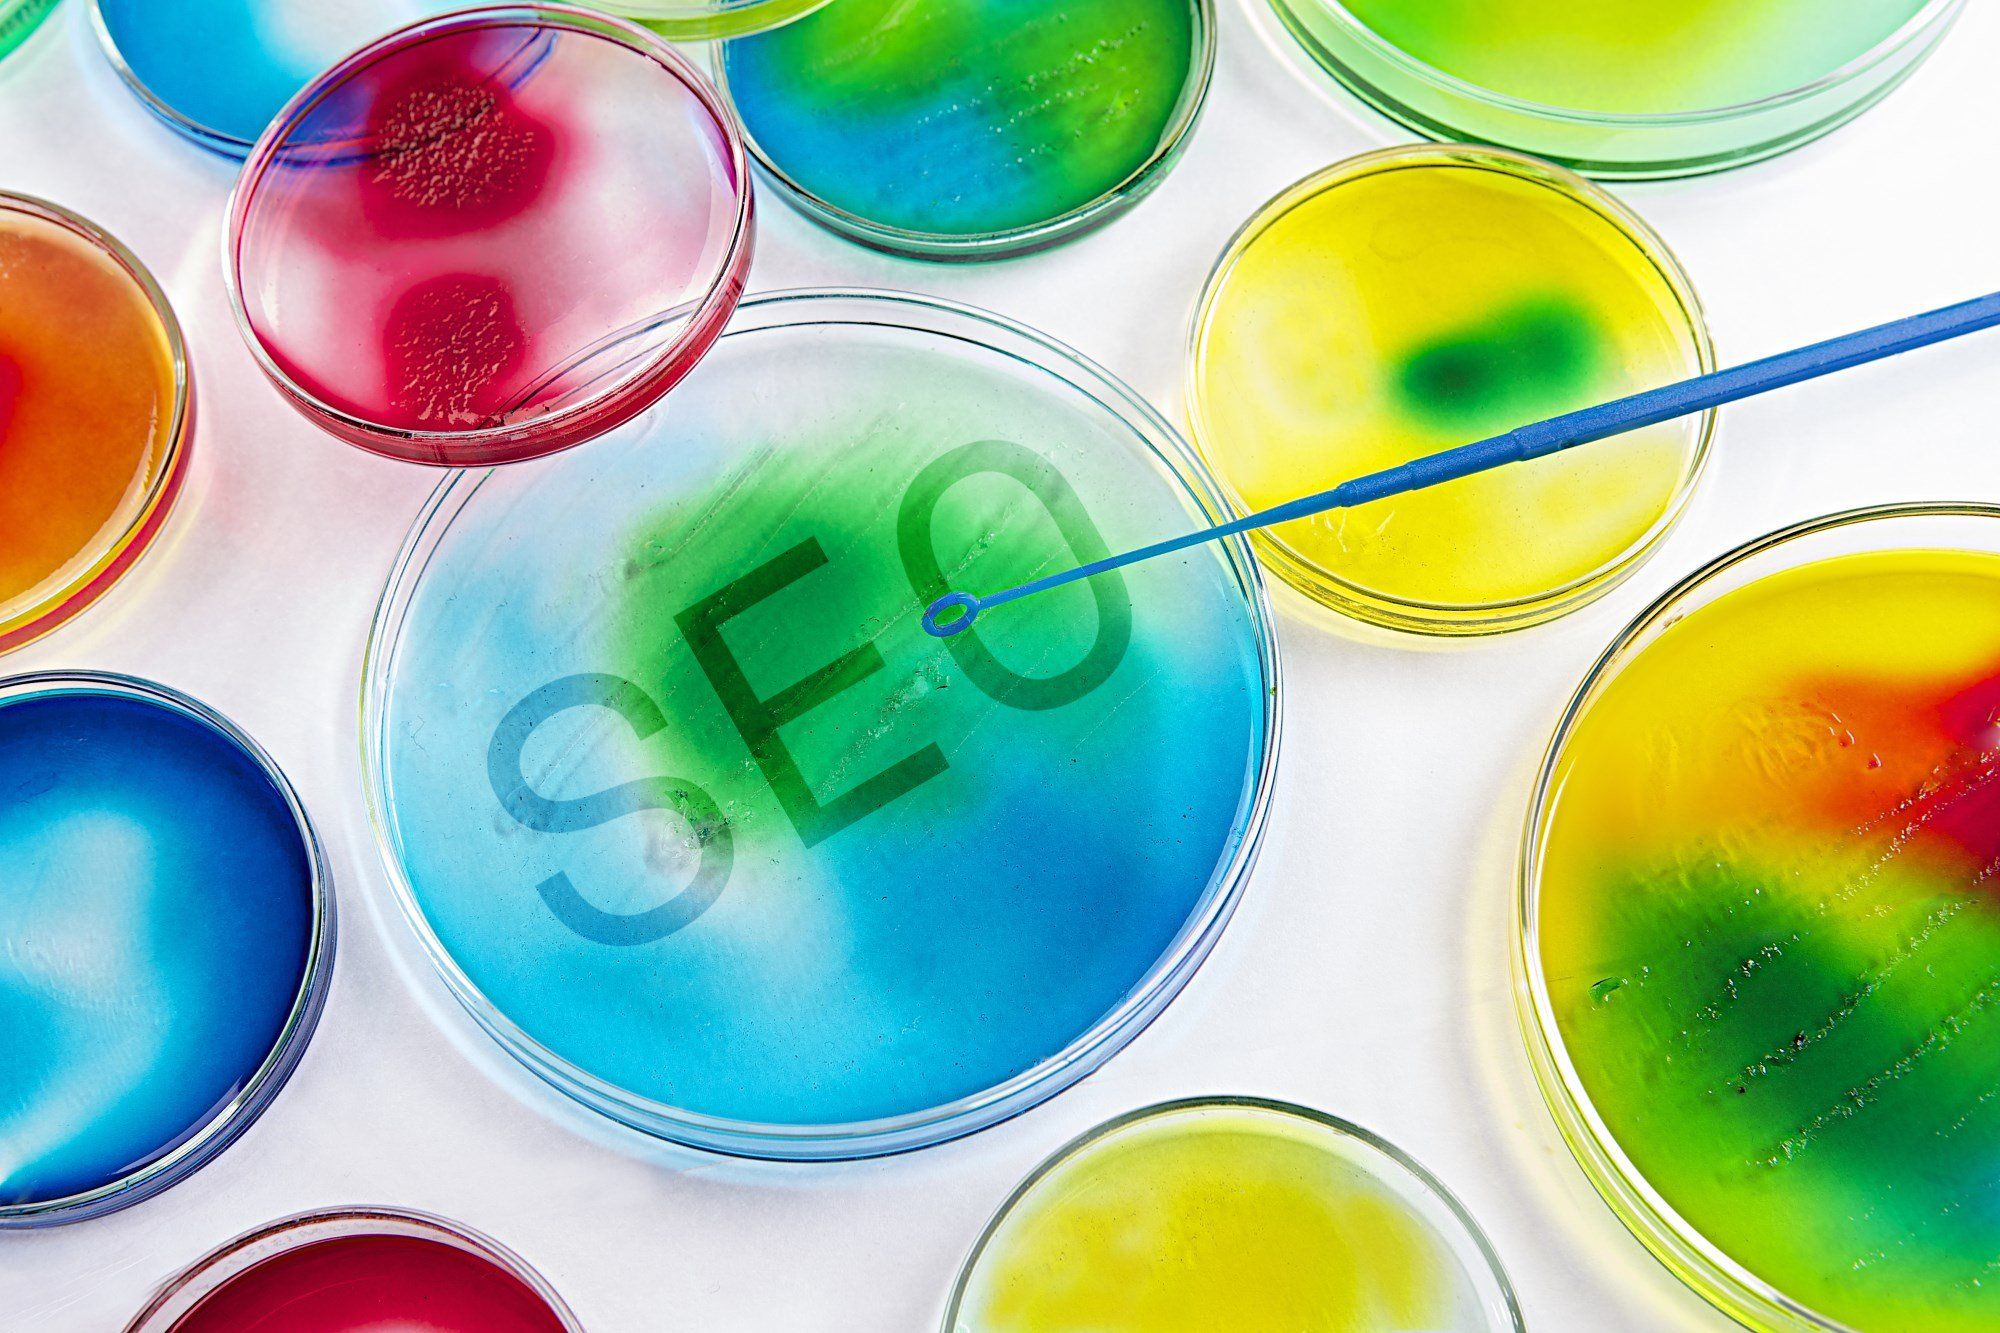

Verbeter je SEO score, verwijder alle 302 redirects
Duidelijker kan ik de titel niet maken. Wil je positie in de zoekresultaten een beetje opkrikken? Hier wat tips om de 302 redirects aan te pakken.
Wanneer je al enige tijd een domein met website hebt, misschien al een keer een nieuwe site hebt gebouwd of laten bouwen (die er weer een andere URL structuur op na houdt), is het een quick-win om de http-status codes eens na te lopen voor je belangrijkste pagina's.
Vaak kun je dit binnen het CMS bekijken en/of aanpassen, soms via de admin-interface van je server beheer-tools, en soms moet je dit binnen de code van je Apache of Nginx software aanpassen.
Wat betekenen 302 en 301 verwijzingen voor je SEO?
Waarom deze actie? Een 302 redirect of verwijzing betekent een tijdelijke verwijzing van een bepaalde URL naar een andere.
Het kan bijvoorbeeld zijn dat je een pagina aan het verbeteren bent en bezoekers tijdelijk naar een andere pagina laat gaan totdat je de aanpassingen hebt doorgevoerd. Daarna hef je die weer op en alles is weer zoals het is. Niks aan de hand, je wilde de tijdelijke landingspagina toch niet mee laten tellen in de zoekresultaten voor de langere termijn.
Wat helaas ook vaak het geval is, is dat er tijdelijke verwijzingen worden geplaatst voor iets wat eigenlijk permanent is. En wat er bovenop komt kijken: Google en andere zoekmachines laten bij een 302 verwijzing de URL nog bestaan en dragen geen waarde over naar de verwezen pagina wanneer het op SEO scores aankomt. Deze pagina met 302 behoudt dus zijn SEO score en draagt niets over naar de uiteindelijke pagina waarnaar verwezen wordt. Zonde!
In dit laatste scenario is er vaak een simpele en snelle winst te behalen, door deze 302 permanent te maken en er dus een 301 van te maken.
Hierdoor wordt de SEO score wel overgedragen door Google en zal de 'oude' pagina (die met de 302 erop) niet meer vernoemd worden in de zoekresultaten.
Welke tools/software maken dit uitzoekwerk makkelijk?
Je kunt dit vrij eenvoudig uitzoeken en testen met de volgende (gratis) tools:
Met Open Site Explorer kun je controleren of een 'oude' URL bijvoorbeeld nog SEO score krijgt toegewezen en of er bijvoorbeeld nog andere sites naar verwijzen.
Daarna kun je, als bovenstaande het geval is (en er is een waardevolle score gevonden) met Redirect Checker controleren hoe de verwijzingen in elkaar steken. Mocht hier een 302 aan te pas komen, kun je actie ondernemen om dit aan te gaan passen. Door deze 302 naar een 301 (permanent) om te zetten, zul je na verloop van tijd een verschil moeten gaan zien bij de URL waar je uiteindelijk naar toe verwijst.
Eventueel kun je bovenstaand ook met Screaming Frog SEO Spider doen, waar je net even wat meer en extra informatie over relevante pagina's en meta info krijgt.
Het loont gewoon om deze check even te doen wanneer je een domein met historie beheert, of als je recentelijk een nieuwe site hebt uitgerold of flink wat pagina's hebt aangepast en URL structuren hebt veranderd.
Ook als je geen 302 vindt, loont het om dan na te gaan of voor alle URLs waaronder de inhoud van je pagina ooit is geïndexeerd, goed te laten doorverwijzen met een 301 redirect. Je loopt gewoon kansen mis om goed in de resultaten naar voren te komen!
Additie op basis van een lezer: Websiteplanet.com/redirected
Deze tool is ook gratis en bevat geen reclames.